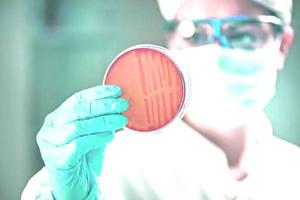

Más leídas

Actualidad | Pág. 2
Gobernador regional define las prioridades para 2023: seguridad y creación de empleos

Deportes | Pág. 17
Sin "tapado": Cobreloa sigue a la espera de más fichajes
Opinión | Pág. 13
Correo
Opinión | Pág. 13
Castro no quiere seguir el modelo de la URSS
Opinión | Pág. 13
Irán: gran estallido de violencia en todo el país

Espectáculos | Pág. 14
Discos de Metallica, Sam Smith y Del Rey animarán 2023 a la espera de Rihanna

Espectáculos | Pág. 14
Santaferia propone la banda sonora para sacar la vida adelante
Servicios | Pág. 16
Alabanza del pimiento.
Servicios | Pág. 16
SUDOKU

Deportes | Pág. 17
Asamblea de socios quedó definida para el 20 de enero en el Sindicato 2 de Codelco

Deportes | Pág. 18
Listos los preparativos para el último adiós de Pelé en el funeral más grande Brasil
Opinión | Pág. 12
Urgencias que marcan llegada del nuevo año
Deportes | Pág. 18
Minuto de silencio en asunción de Lula

Deportes | Pág. 18
Mundial 1962: la gran decepción de Pelé en la historia de la Copa

Deportes | Pág. 18
Pelé y la promesa incumplida de Spielberg sobre una película en la luna

Deportes | Pág. 19
Argentina y España, los primeros eliminados en la United Cup

Deportes | Pág. 19
Ben Brereton inicia el año siendo clave en victoria del Blackburn

Deportes | Pág. 19
Prensa española asegura que Claudio Bravo está cerca de renovar con Betis

Deportes | Pág. 19
Se complica continuidad del goleador Juan Martín Lucero en Colo Colo

Deportes | Pág. 19
"Chaleco" López ganó la primera etapa del Dakar y es líder en vehículos ligeros

Opinión | Pág. 12
¡Viva la vida!

Opinión | Pág. 12
Compensaciones BCI

Actualidad | Pág. 2
Trabajadores de Chuquicamata se capacitan en RCP y maniobra de Heimlich
Actualidad | Pág. 6
Gobierno pide retomar mesa de seguridad y Chile Vamos anuncia agenda paralela

Actualidad | Pág. 3
Balance: Carabineros desbarató 19 organizaciones criminales en la Provincia de El Loa durante 2022

Actualidad | Pág. 3
Detienen a personas por contrabando de cigarros

Actualidad | Pág. 3
Minvu intervendrá dos barrios en la región y uno pertenece a Calama

Actualidad | Pág. 4
Diagnósticos de covid-19 aumentaron en 283% en el año 2022 en relación al periodo 2021

Actualidad | Pág. 4
Una mujer fue la primera recién nacida de este año en el Hospital de Calama

Actualidad | Pág. 5
"Aún existe una brecha de género en las ciencias"

Actualidad | Pág. 5
"Tenemos una gran deuda social con la investigación"
Actualidad | Pág. 6
Indultado por Boric al salir de la cárcel: "Los insurrectos no nos calmamos"

Actualidad | Pág. 7
Cinco muertos en accidentes de tránsito en feriado
Actualidad | Pág. 11
Dos grandes barreras de protección que podemos poner para prevenir el cáncer
Actualidad | Pág. 7
Sueldo mínimo sube a $410 mil por incremento de la inflación

Actualidad | Pág. 7
Onemi ahora es Senapred: buscará prevenir los desastres

Actualidad | Pág. 8
Lula da Silva asume el poder y celebra: Brasil "vuelve a ser un país soberano"

Actualidad | Pág. 8
Presidente Boric viajó con Ricardo Lagos a "histórica" investidura de Lula da Silva

Actualidad | Pág. 9
Hoy comienzan los tres días de despedida de Benedicto XVI
Actualidad | Pág. 9
Ucrania recibe 2023 con masivo ataque de misiles rusos y drones iraníes

Actualidad | Pág. 9
"Señor te amo", fueron las últimas palabras del Papa emérito

Actualidad | Pág. 10
Así se vivió la llegada del año 2023 en el mundo

Contraportada | Pág. 20
Mecanismo genético en bacterias podría explicar resistencia a los antibióticos